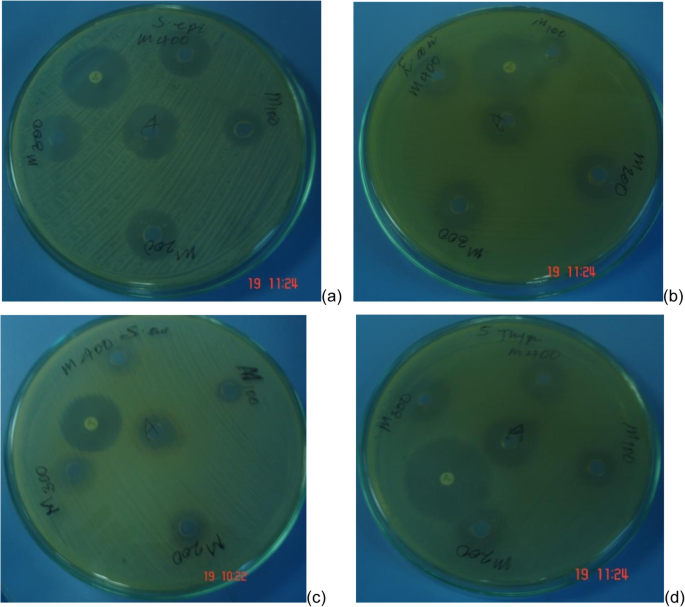
figure 6

- Research
- Open access
- Published:
Mono and binuclear cobalt(II) mixed ligand complexes containing 1,10-phenanthroline and adenine using 1,3-diaminopropane as a spacer: synthesis, characterization, and antibacterial activity investigations
Future Journal of Pharmaceutical Sciences volume 6, Article number: 13 (2020)
Abstract
Background
Coordination compounds, in particular cobalt(II) mixed ligand complexes containing 1,10-phenantroline, have drawn the attention of many investigators as some of them are showing antimicrobial activities.
Result
Herein, we report three novel mixed ligand complexes of cobalt(II) having the formulae [Co(L1)2(H2O)2]Cl2, [Co(L1)2(L2)(H2O)]Cl2 and [Co2(L1)4(L2)2(L3)]Cl4 (L1 = 1,10-phenanthroline, L2 = adenine, L3 = 1,3-diaminepropane) were synthesized and characterized by elemental analysis, conductivity measurement, infrared, and UV-Vis spectroscopic techniques. Octahedral geometries are proposed to all the complexes. In vitro antibacterial activities of the ligands, salt, and metal complexes were tested on four pathogenic bacteria (Staphylococcus aureus, Salmonella typhus, Escherichia coli, and Staphylococcus epidermis) using disc diffusion method.
Conclusions
It is interesting to note that the newly synthesized cobalt(II) complexes are active against gram negative bacteria (Escherichia coli and Klebsiella pneumoniae) even though cobalt(II) complexes are well known for their activity against gram positive bacteria.
Background
On coordination with suitable ligands, it is possible to impose a set of desired properties on transition metals for specific applications. It is achieved by altering properties such as the stability of different oxidation states, solvophilicity, electrophilic, and nucleophilic properties of the metal ions. It can be done by tuning through variation of the metal and the choice of one of the vast array of ligands available for complexation [1,2,3]. While coordinating, the properties of the ligands themselves are also modified. For instance, the pharmacological activities and their crucial role in DNA/RNA base pairing through several hydrogen-bonding patterns of free purines such as adenine can significantly change after complex formation [4,5,6]. 1,10-Phenanthroline significantly changes its toxicity when coordinated to metals [7, 8]. Based on this, synthesis of different coordination compounds with one or more metal centers by ligand tailoring has become a fascinating research field. Designing such coordination compounds for therapeutic applications has been part of this activity [9,10,11,12,13,14,15,16,17,18].
A good number of mononuclear [4, 7, 19, 20] and binuclear [21,22,23,24,25] mixed ligand metal complexes have been reported. In particular, the bioinorganic chemistry of cobalt(II) complexes have drawn the attention of many investigators [26,27,28]. This is because of the fact that cobalt complexes are showing antibacterial [29] and antifungal [30] activities. However, in most reports, Co(II) complexes are unable to show activities against Gram-negative bacteria [31]. This is probably due to their inability to penetrate the cell wall of these bacteria [32,33,34], which demands the fine-tuning of Co(II) complexes employing novel ligand functionalities, thereby achieving variable compositions. In this context, two mononuclear and one binuclear Co(II) complexes have been synthesized from 1,10-phenanthroline, adenine, and 1,3-diaminopropane, and their biological activities were studied and are compared with commercially available antibiotics.
1,10-Phenanthroline (Fig. 1) is rigid planar, chelating bidentate ligand. The stacking interaction of 1,10-phenanthroline with DNA base pairs makes it applicable in medical fields [35, 36].
Adenine (Fig. 2) is a purine nucleotide and can exist in either amino or imino forms. However, the amino tautomer is more stable and therefore predominates under the cellular conditions [37]. Its exocyclic amino group is less likely to coordinate since the lone pair of electrons is largely delocalized into the ring by resonance (Fig. 3). Because it is free from resonance and steric hindrance, the best coordination site for adenine is N7 of the imidazole ring [38].
Metal complexes of adenine have considerable interest in the design of model complexes involving purines which could mimic interactions of metal ions with DNA [39].
1,3-Diaminopropane is a bidentate ligand (Fig. 4) which is used as a precursor for pharmaceutical, agrochemical, and organic industries [40, 41].
Methods
Materials
The metal salt is CoCl2.6H2O (Analar BDH) and the ligands are 1,10-phenanthroline monohydrate (BDH), adenine (99%, ACROS), and 1,3-diaminopropane (ACROS). Muller Hinton Agar and barium chloride (BLULUX Laboratories Ltd, India) were used as such. All other solvents used are of reagent quality.
Physical methods of analysis
All the complexes were analyzed for their metal and halide contents by the conventional methods. The molar conductance was measured using 10−3 M solution for each complex in deionized water with JENWAY 4200 conductivity meter at room temperature. The electronic spectra were recorded in the 50,000–12,500 cm−1 region on Sanyo SP65 UV/VIS spectrophotometer. IR spectra were recorded using KBr discs in the 4000–400 cm−1 region on AVATAR 330 FT-IR, Thermo Nicolet spectrophotometer. C, H, and N content determination were performed on a Perkin Elmer 2400 elemental analyzer.
Synthesis of complexes
Synthesis of [Co(L1)2(H2O)2]Cl2 (1)
A methanolic solution of 1,10-phenanthroline monohydrate (1 g, 5 mmol) was added to a methanolic solution of CoCl2.6H2O(0.6 g, 2.5 mmol) being stirred magnetically in an ice bath. It was further allowed to stir for 1 h at room temperature. It was then refluxed for one more hour and allowed to cool to room temperature. On evaporating the resultant solution, a yellow powder, which was obtained and washed with acetone several times to remove any unreacted 1,10-phenanthroline. It was then re-crystalized from methanol (yield, 1.14 g; 85.84%).
Synthesis of [Co (L1)2(L2)(H2O)]Cl2 (2)
To an aqueous solution of 1 (0.3 g, 0.57 mmol) being stirred magnetically in oil bath at 60 °C, an aqueous solution of adenine (0.077 g, 0.57 mmol) was added. A deep reddish brown homogeneous solution was obtained. The solvent was removed under vacuum. Yellowish orange powder was collected and washed several times with acetonitrile (yield, 0.23 g; 62.9%).
Synthesis of [Co2(L1)4(L2)2(L3)]Cl4 (3)
To an aqueous solution of 2 (0.320 g, 0.49 mmol) being stirred magnetically in water bath at 10 °C, an aqueous solution of slightly excess 1,3-diaminopropane (0.022 g, 25 μL) was added. A deep reddish brown homogeneous solution was obtained. The stirring was continued for one more hour. The solvent was removed from the resulting solution under vacuum. A red-brown powder was obtained and was washed with acetone several times (yield, 0.266 g; 73%).
Results
Synthesis and characterization studies
The formation of the complexes can be represented by the following equations (scheme 1):
CoCl2.6H2O + 2L1 → [Co(L1)2(H2O)2]Cl2 (1)
[Co(L1)2(H2O)2]Cl2 + L2 → [Co(L1)2L2H2O]Cl2 (2)
[Co(L1)2L2H2O]Cl2 + L3 → [Co2(L1)4(L2)2(L3)]Cl4 (3)
where L1 = 1,10-phenantroline, L2 = Adenine, and L3 = 1,3-diaminopropane.
All the synthesized complexes are soluble in most of the polar solvents including water while insoluble in most of the non-polar solvents and exhibit high melting point.
From elemental analysis and the conductance measurements, the complexes can be formulated as [Co(L1)2(H2O)2]Cl2 (1), [Co(L1)2(L2)(H2O)]Cl2 (2), and [Co2(L1)4(L2)2(L3)]Cl4 (3) where L1 = 1,10-phenantroline, L2 = thymine, and L3 = 1,3-diaminopropane (Table 1).
The important IR spectral band of the ligands and the corresponding complexes are presented in Table 2.
The electronic spectra of the ligands and the corresponding complexes 1, 2, and 3 with tentative assignments are presented in Table 3.
It has been observed that complex 3 is having better biological activity than the corresponding precursor complexes 1 and 2 against all the bacterial strains in the present study (Table 4).
The activity indexes of the present study with respect to the commercial antibiotic demonstrated that the complexes are less active. However, it is evident that the MIC of the binuclear complex 3 is better than complexes 1 and 2 (Table 5).
Spectroscopic results
Infrared spectra
The observed shifts in band positions are a clear indication that the ligands are coordinated to the Co(II). The bands at 1620 cm−1(s) and 1585 cm−1(s), characteristic for νC=C and νC=N, stretching vibration respectively in 1,10-phenanthroline monohydrate are shifted to 1628 cm−1(w) and 1522 cm−1(w), respectively, in [Co(L1)2(H2O)2]Cl2. The shift in frequency may indicate the change in the bond order in C=C and C=N following the coordination. However, the decrease in their intensity indicates the formation of rigid and symmetric structure. The coordination of adenine to Co(II) in [Co(L1)2(H2O)2]Cl2 is evident that all its characteristic vibration frequencies appear in [Co(L1)2(L2)(H2O)]Cl2. The relatively higher electronic concentration in N7 in the imidazole ring is the most preferable site of coordination [38]. The characteristic vibration frequencies of adenine appeared dominantly. This is probably due to the relative vibration freedom of adenine in the complex compared to the rigid and symmetric configuration of the rest of the complex. The strong and broad band ranging from 3403 to 3043 cm−1 is due to the additive combination of the characteristic vibrations of primary amine from adenine and 1,3-diaminopropane which is a strong confirmation of the coordination of 1,3-diaminopropane to [Co(L1)2(L2)(H2O)]Cl2. Moreover, the increase in strength and broadness of the band in the frequency range 3403–3043 cm−1as well as the appearance of new bands at the vibration frequency 539 cm−1 is due to Co–N bond confirms the coordination of 1,3-diaminpropane in the formation of the binuclear complex.
Electronic spectra
Inter-ligand and simple characteristic d-d transitions are exhibited by the complexes. Significant difference in the band number and position of transition absorption between CoCl2.6H2O, the ligands, and the complexes is observed. This may be as a consequence of different environments around the metal ion following the coordination [42,43,44]. The coordination of the ligands to the metal is demonstrated by the shifts in the maximum absorption wave lengths corresponding to ligand centered π → π*(C=C), π → π*(C=N), n → π*(C=N) as well as metal centered energy states. The absorption band at 37,878 cm−1 of 1,10-phenanthroline due to n → π*(C=N) is shifted to 37,313; 37,174; and 36,764 cm−1 in the complexes 1, 2, and 3, respectively [45]. Furthermore, the single band due to the simple d-d transition in the starting salt CoCl2.6H2O observed at 23,419 cm−1 is changed to triple absorption bands between 44,062 and 13,642 cm−1 is assigned to 4T1g(F) → 4T1g(P), 4T1g(F) → 4A2g(F), and 4T1g(F) → 4T2g(F) transitions, characteristics of octahedral geometry around Co(II) ion. The equatorial orbitals (dx2 − y2) of Co(II) are coordinated to the strong field bidentate 1,10-phenanthroline which results strong and shorter bonds compared to those orbitals in the axial position (dz2) due to Jahn-Teller effect. Consequently, distorted octahedral geometry is achieved. The coordinated 1,10-phenanthroline occupied the base plane with water and adenine occupying the apical position. Based on the above studies, a distorted octahedral geometry is assigned for all the complexes as follows (Fig. 5).
Antibacterial activity
Antibacterial activity is occurring because of the diffusion of the complexes through the lipid membrane of the cells and interacting with the normal activity of the cell. This can be varied by designing the complexes with varying lipophilic properties. The interaction of the complexes with targeted cell could be achieved by tuning the complex in such a way that its components have properties either that bind covalently (irreversible) or interact non-covalently (reversible) or by carrier agents that deliver active ligands in vivo to the biological target [46]. It has been observed that complex 3 showed better biological activities than the precursor complexes 1 and 2 against all the tested strains (Table 4). Based on the proposed structure, it is expected that complex 3 is having configurationally free twisting movement through the bridge, which presumably enhanced its flexibility and in turn enhances the penetration power of the complex into the cytoplasm of the pathogenic cells [47].
Minimum inhibitory concentration (MIC) determination
Minimum inhibitory concentration (MIC) is the lowest concentration that completely inhibited the growth of microorganisms for 24 h. Around 100 μg/mL of complex 3 is sufficient to inhibit the growth of all the tested strains (Fig. 6).
The percentage activity indexes against the reference antibiotic demonstrated that the complexes are less active. However, it is evident that the MIC of the binuclear complex 3 is far better than complexes 1 and 2 (Table 5). This is probably because of bisintercalation due to the two planar intercalating 1,10-phenanthroline ring systems covalently linked 1,3-diaminepropane.
Discussion
All the synthesized complexes are soluble in most polar solvents like acetonitrile, DMSO, and water and insoluble in almost all non-polar solvents. From the elemental analysis and conductivity measurement data, it can be concluded that the complexes can be formulated as Co(L1)2(H2O)2Cl2 (1), Co(L1)2(L2)(H2O)Cl2 (2), and Co2(L1)4(L2)2L3Cl4 (3). The molar conductance data of the complexes 1, 2, and 3 was measured using 10−3 M solution for each complex in water and indicates a 1:2 conducting nature for 1 and 2 while a 1:4 conducting nature for 3. So, the complexes can be formulated as [Co(L1)2(H2O)2]Cl2 (1), [Co(L1)2(L2)H2O]Cl2 (2), and [Co2(L1)4(L2)2L3]Cl4 [48, 49]. The results obtained from infrared and electronic spectra are in conformity with the above derived formulae.
Based on the analytical and spectroscopic results presented, a distorted octahedral geometry is assigned for all the complexes. The antibacterial activity studies revealed that all the synthesized complexes exhibited antibacterial activity against even the most drug resistant Klebsiella pneumoniae which makes them as potential wide range antibacterial drugs, after in vivo cytotoxicity investigations. The major limitations of these synthesized complexes are that they show minimum inhibition zone than the reference antibiotic ciprofloxacin. However, their antibacterial activity can be improved by tuning the ligand functionality.
Conclusion
Novel mixed ligand Co(II) complexes have been prepared and characterized by various physical, chemical, and spectroscopic techniques. An octahedral geometry has been suggested for all synthesized complexes. Presumably, adenine is coordinated to Co(II) through its ring nitrogen (N7). Consequently, the complexes are expected to interact atleast by hydrogen bonding with thymine residue of the bacteria genetic material. Furthermore, the synthesis resulted in the alteration of the properties of the starting materials. One advantage of this alteration is to enable the complexes to penetrate the cell wall of the pathogenic cells and consequently, interfere in their normal system to inhibit their growth. This was confirmed from the in vitro antibacterial test results. The result revealed that all the synthesized complexes exhibited antibacterial activity against even the most drug resistant Klebsiella pneumoniae which makes them, potentially wide range antibacterial drugs, after in vivo cytotoxicity investigations.
Even though the ligands and the synthesized complexes show antibacterial activity, they are not recommended as antibiotics as compared to the reference ciprofloxacin as the antibacterial activity is less for the complexes than the control. So, more work is needed to be done with respect to the variation of the ligands by causing conformational change to the complexes to achieve a good antibiotic drug by the complexes for therapeutic applications.
Availability of data and materials
Data are available from the corresponding author upon request.
References
Boyer JL, Rochfor J, Tsai M-K, Muckerman JT, Fujita E (2010) Ruthenium complexes with non-innocent ligands: electron distribution and implications for catalysis. Coord Chem Rev 254:309–330
Goo YR, Maity AC, Cho KB, Lee YM, Seo MS, Park YJ, Cho J, Wonwoo NW (2015) Tuning the reactivity of chromium(III)-superoxo species by coordinating axial ligands. Inorg Chem 54:10513–10520
Tolman CA (1977) Steric effects of phosphorus ligands in organometallic chemistry and homogeneous catalysis. Chem Rev 77:313–348
Abebe A, Tamiru G (2018) Hexacationic coordination compound from Co(II) and a cationic ligand derived from 4,4′-bipyridine: synthesis, characterization and investigation for biological application. Cogent Chemistry 4:156–162
Mohapatra B, Verma S (2013) Crystal engineering with modified 2-aminopurine and Group 12 metal ions. Cryst Growth Des 13:2716–2721
Patel DK, Domínguez-Martín A, del Pilar B-BM, Choquesillo-Lazarte D, Nurchi VM, Niclós-Gutiérrez J (2012) Metal ion binding modes of hypoxanthine and xanthine versus the versatile behavior of adenine. Coord Chem Rev 256:193–211
Abebe A, Hailemariam T (2016) Synthesis and assessment of antibacterial activities of ruthenium (III) mixed ligand complexes containing 1, 10-phenanthroline and guanide. Bioinorg Chem Appl 2016:1–9
Lawrence GA (2010) Introduction to coordination chemistry. John Wiley & Sons, University of Newcastle, Newcastle
Motswainyana WM, Ajibade PA (2015) Anticancer activities of mononuclear ruthenium (II) coordination complexes. Advances in Chemistry 2015:1–21
Rafique S, Idrees M, Nasim A, Akbar H, Athar A (2010) Transition metal complexes as potential therapeutic agents. Biotechnology and Molecular Biology Reviews 5:38–45
Bruijnincx PC, Sadler PJ (2009) Controlling platinum, ruthenium, and osmium reactivity for anticancer drug design. Adv Inorg Chem 61:1–62
Bruijnincx PC, Sadler PJ (2008) New trends for metal complexes with anticancer activity. Curr Opin Chem Biol 12:197–206
Suntharalingam K, Johnstone TC, Bruno PM, Lin W, Hemann MT, Lippard SJ (2013) Bidentate ligands on osmium (VI) nitrido complexes control intracellular targeting and cell death pathways. J Am Chem Soc 135:14060–14063
Carreira M, Calvo-Sanjuán R, Sanaú M, Marzo I, Contel M (2012) Organometallic palladium complexes with a water-soluble iminophosphorane ligand as potential anticancer agents. Organometallics 31:5772–5781
Mishra A, Jung H, Park JW, Kim HK, Stang PJ, Chi KW (2012) Anticancer activity of self-assembled molecular rectangles via arene–ruthenium acceptors and a new unsymmetrical amide ligand. Organometallics 31:3519–3526
Vela L, Contel M, Palomera L, Azaceta G, Marzo I (2011) Iminophosphorane-organogold (III) complexes induce cell death through mitochondrial ROS production. J Inorg Biochem 105:1306–1313
Allardyce CS, Dyson PJ (2016) Metal-based drugs that break the rules. Dalton Trans 45:3201–3209
Kratz FL, Messori F (1993) Spectral characterization of ruthenium (III) transferrin. J Inorg Biochem 49:79–82
Pasdar H, Foroughifar N, Hedayati SB (2015) Investigation into the antibacterial activity of metal complexes derived from substituted chromone in comparison with tetracycline, and cephradine as standard drugs against Escherichia coli and Staphylococcus aureus. Journal of Medical Microbiology and Infectious Diseases 3:75–79
Ghatole AM, Lanjewar KR, Gaidhane MK (2012) Syntheses, characterization, antimicrobial activity of copper (II), zinc (II) and cobalt (II)complexes of the bi-dented substituted 2-((E)-2-((2-chloro-6-ethoxyquinolin-3-yl)methyleneamino) thiazol-4-yl)phenol having ON donor sites. J Pharm Res 5:2758–2762
Patel MN, Chhasatia MR, Gandhi DS (2009) Interaction of drug based binuclear mixed-ligand complexes with DNA. Bioorg Med Chem 17:5648–5655
Nfor EN, Keenan LL, Nenwa J, Ndifon PT, Njong RN, Dzesse CN, Offiong OE (2014) A novel mixed ligand dinuclear complex of cobalt (II): synthesis, characterization and magnetic studies. Crystal Structure Theory and Applications 3:22–29
Gurumoorthy P, Ravichandran J, Rahiman AK (2014) Mix ed-ligand binuclear copper (II) complex of 5-methylsalicylaldehyde and 2, 2′-bipyridyl: Synthesis, crystal structure, DNA binding and nuclease activity. J Chem Sci 126:783–792
Bhatt VD, Ram SR (2012) Preparation and properties of dinuclear Schiff base complexes from salicylaldehyde and 2-aminophenol complexes of Cu(II), Co(II) and Ni(II). Chem Sci J 2012:1–11
Panda N, Tripathy SK, Behera NK, Panda AK, Das PK (2015) Synthesis, spectroscopic and anti-microbial studies of binuclear Schiff base complexes derived from the ligand prepared from isoniazid and benzilmonohydrazone. International Journal of Innovative Science, Engineering & Technology 2:783–795
Iqbal J, Tirmizi SA, Wattoo FH, Imran M, Wattoo MHS, Sharfuddin S, Latif S (2006) Biological properties of chloro-salicylidene aniline and its complexes with Co(II) and Cu(II). Turk J Biol 30:1–4
Singh K, Kumar Y, Puri P, Singh G (2012) Spectroscopic, thermal, and antimicrobial studies of Co(II), Ni(II), Cu(II), and Zn(II) complexes derived from bidentate ligands containing N and S donor atoms. Bioinorg Chem Appl 2012:1–10
Ejidike IP, Ajibade PA (2015) Synthesis, characterization, antioxidant, and antibacterial studies of some metal(II) complexes of tetradentate Schiff base ligand: (4E)-4-[(2-(E)-[1-(2, 4-dihydroxyphenyl) ethylidene] aminoethyl) imino] pentan-2-one. Bioinorg Chem Appl 2015:1–9
Saha S, Dhanasekaran D, Chandraleka S, Thajuddin N, Panneerselvam (2010) A synthesis, characterization and antimicrobial activity of cobalt metal complex against drug resistant bacterial and fungal pathogens. Adv Biol Res 4:224–229
Zhong W, Zishen W, Zhenhuan Y, Zhifong L, Xinde Z, Qinghua H (1994) Synthesis, characterization and antifungal activity of copper(II), zinc(II), cobalt(II) and nickel(II) complexes derived from 2-chlorobenzaldehyde and glycine. Synthesis and Reactivity in Inorganic and Metal-Organic Chemistry 24:1453–1460
Asia M, Shalash HI, Abu A (2015) Synthesis, crystallographic, spectroscopic studies and biological activity of new cobalt(II) complexes with bioactive mixed sulindac and nitrogen-donor ligands. Chemistry Central Journal 11:1–9
Gao Y, van Belkum MJ, Stiles ME (1999) The outer membrane of Gram-negative bacteria inhibits antibacterial activity of brochocin-C. Appl Environ Microbiol 65:4329–4333
Stănilă A, Braicu C, Stănilă S (2011) Antibacterial activity of copper and cobalt amino acids complexes. Notulae Botanicae Horti Agrobotanici Cluj-Napoca 39:124–129
Podunavac-Kuzmanović SO, Leovac VM, Cvetković DD (2008) Antibacterial activity of cobalt(II) complexes with some benzimidazolederivatives. Journal of the Serbian Chemical Society 73:1153–1160
Mahalakshmi R, Raman N (2016) A therapeutic journey of mixed ligand complexes containing 1, 10-phenanthroline derivatives: a review. Int J Curr Pharm Res 8:1–6
Chandraleka S, Chandramohan G (2014) Synthesis, characterization and thermal analysis of the copper(II) complexes with 2, 2-bipyridyl and 1, 10-phenanthroline. Afr J Pure Appl Chem 8:162–175
Fonseca GC, Bickelhaupt FM, Saha S, Wang F (2006) Adenine tautomers: relative stabilities, ionization energies, and mismatch with cytosine. J Phys Chem 110:12–20
Lippard SJ, Berg JM (1994) Principles of bioinorganic chemistry. University Science Books, Mill Valley, California
Shamsi MH, Kraat HB (2013) Interactions of metal ions with DNA and some applications. J Inorg Organomet Polym Mater 23:4–23
Shen Y, Huang R, Li Y, Yao S (2011) Synthesis and photochromic properties of 1, 3-diaminopropane-induced MoO3 powder. Appl Surf Sci 258:414–418
Asokan A, Varghese B, Caneschi A, Manoharan PT (1998) A novel polymer of a binuclear nickel(II) complex bridged by 1, 3-diaminopropane: structure and magnetism. Inorg Chem 37:228–232
Housecroft CE, Sharpe AG (2005) Inorganic chemistry. Pearson Education, England
Gary LM, Donald AT (1994) Inorganic chemistry. Pearson Education International, St. Olaf College, Northfield, Minnesota
Yosef B, Atakilt A, Thomas M, Wolfgang L (2019) Synthesis, characterization and antimicrobial activities of new mixed ligand complexes of copper(II) with 1,10-phenanthroline and thymine. Journal of Transition Metal Complexes 2:1–6
Atakilt A, Abreham S, Silesh A, Mulugeta K (2017) Copper(II) mixed-ligand complexes containing 1, 10-phenanthroline, adenine and thymine: Synthesis, characterization and antibacterial activities. Chem Int 3:230–239
Komor AC, Barton JK (2013) The path for metal complexes to a DNA target. Chem Commun 49:3617–3630
Feng G, Shi Y, Zhang L, Shi R, Huang W, Wang R (2017) Air-oxidation from sulfur to sulfone-bridged Schiff-basemacrocyclic complexes showing enhanced antimicrobial activities. Sci Rep 7:1–6
Bard AJ, Faulkner LR, Leddy J, Zoski CG (1980) Electrochemical methods: fundamentals and applications. Wiley, New York
Atkins PW (1994) Physical chemistry. Oxfored University Press, Oxford
Acknowledgements
The authors are grateful to Bahir Dar University and Addis Ababa Science and Technology University for providing all necessary facilities.
Funding
Not applicable.
Author information
Authors and Affiliations
Contributions
The authors YB, MB, and TG participated in conceptualizing, executing, analyzing, and writing the original draft except the authors AA, MT, and WL who were responsible for supervision, editing, and reviewing of this article. Also all authors have read and approved the manuscript.
Corresponding authors
Ethics declarations
Ethics approval and consent to participate
Not applicable.
Consent for publication
Not applicable.
Competing interests
The authors declare that they have no competing of interest.
Additional information
Publisher’s Note
Springer Nature remains neutral with regard to jurisdictional claims in published maps and institutional affiliations.
Rights and permissions
Open Access This article is licensed under a Creative Commons Attribution 4.0 International License, which permits use, sharing, adaptation, distribution and reproduction in any medium or format, as long as you give appropriate credit to the original author(s) and the source, provide a link to the Creative Commons licence, and indicate if changes were made. The images or other third party material in this article are included in the article's Creative Commons licence, unless indicated otherwise in a credit line to the material. If material is not included in the article's Creative Commons licence and your intended use is not permitted by statutory regulation or exceeds the permitted use, you will need to obtain permission directly from the copyright holder. To view a copy of this licence, visit http://creativecommons.org/licenses/by/4.0/.
About this article
Cite this article
Abebe, A., Bayeh, Y., Belay, M. et al. Mono and binuclear cobalt(II) mixed ligand complexes containing 1,10-phenanthroline and adenine using 1,3-diaminopropane as a spacer: synthesis, characterization, and antibacterial activity investigations. Futur J Pharm Sci 6, 13 (2020). https://doi.org/10.1186/s43094-020-00030-4
Received:
Accepted:
Published:
DOI: https://doi.org/10.1186/s43094-020-00030-4